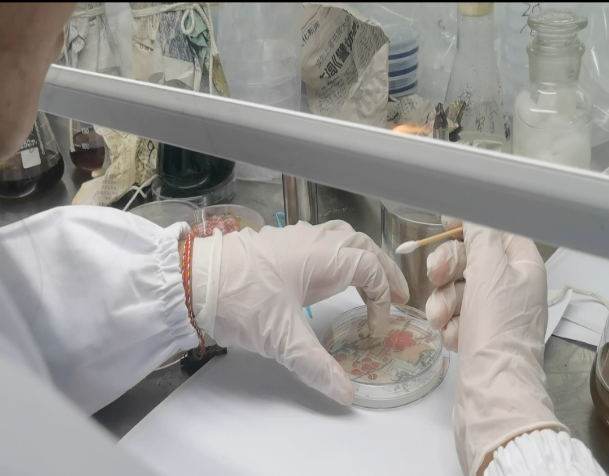

400-081-4789
400-081-4789Information Center
首頁 / 信息中心 / 行業新聞
時間:2023-11-30 來源:沈陽藥科大學 點擊:1128次
第五屆“君立康杯”
微生物設計大賽
近日,沈陽藥科大學第五屆 “君立康杯”微生物藝術設計大賽決賽在我校圖書館國為學術廳舉辦。本項賽事是由教務處、生命科學與生物制藥學院主辦,生命科學與生物制藥學院團委、生物學實驗教學中心、微生物資源庫承辦的一項綜合性學術競賽。本次大賽共收到百余支團隊的創意作品,經過預賽和復賽的激烈角逐,最終共有二十支隊伍突出重圍,進入校賽決賽。

01
預賽階段
在培養皿中使用微生物作畫是考驗同學們專業知識、實驗技能與創造力和想象力的一項活動。同學們展開想象的翅膀各顯神通,創造出了許多創意十足的設計圖。

02
復賽階段
同學們發揮創新精神,利用所學微生物基礎知識,運用各種各樣的菌種,于一方天地之中繪出了一個個奇思妙想的世界,呈現出了豐富多彩的微生物作品。

參賽同學在培養皿上繪圖過程
03
決賽階段
此次進入決賽的二十支隊伍作品類型多元,主題豐富,參賽選手思維活躍,立意精妙,面對評委老師們提出的問題,參賽選手們從容應對、積極作答,體現了良好的專業素養。


大賽優秀作品展示
此次大賽的開展,既加強了青年學生的創新思維和動手能力,也提升了青年學生對專業知識的深刻理解,通過微生物在培養皿上進行藝術創作的方式,將在校所學與生活、藝術、文化等各個層面相結合,有力提升了青年學生的實踐創新能力。學校將以開展此次活動為契機,進一步深化“五育并舉”育人理念,加快培養具有創新思維和創新實踐能力的藥學人才。
